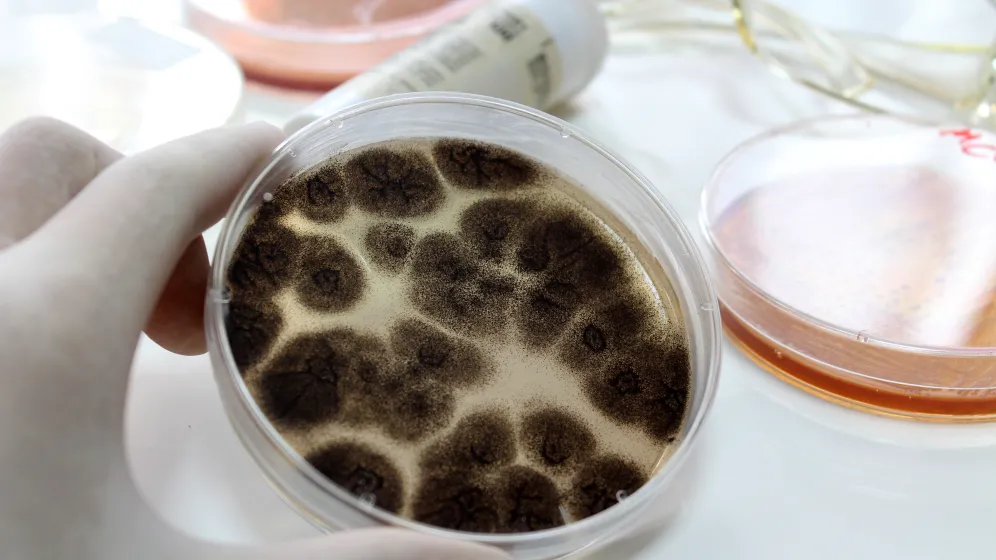
Adobe

Grzybice układowe – niedoceniane zagrożenie
Autorka: Luiza Łuniewska
Według najnowszych badań inwazyjne grzybice mogą odpowiadać nawet za 3,8 miliona zgonów rocznie na świecie. Jeszcze niedawno uznawano je za choroby rzadkie i marginalne, „przywleczone z tropików” - dziś coraz częściej pojawiają się w szpitalach, gdzie atakują pacjentów z osłabioną odpornością.
W świecie medycyny niewiele problemów budzi dziś tyle niepokoju, co grzybice układowe — choroby, które długo pozostawały poza centrum zainteresowania badaczy.
Według najnowszych danych opublikowanych przez zespół prof. Davida W. Denninga z University of Manchester w „The Lancet Infectious Diseases”, grzybice układowe stanowią obecnie jedno z najbardziej niedocenianych zagrożeń dla zdrowia publicznego na świecie. Szacuje się, że każdego roku na ciężkie infekcje grzybicze zapada ponad 6,5 miliona osób, a blisko 3,8 miliona z nich umiera — z czego aż dwie trzecie zgonów można bezpośrednio przypisać działaniu patogenów grzybiczych. Autorzy zwracają uwagę, że globalna śmiertelność związana z grzybicami niemal się podwoiła w ciągu ostatniej dekady. Jak podkreśla prof. Denning: „to pierwsze globalne, kompleksowe oszacowanie rocznej liczby przypadków chorób grzybiczych. Nadal jednak istnieje wiele niepewności i luk w danych”.
Choć grzybice kojarzą się głównie z infekcjami skóry lub błon śluzowych, ich postacie inwazyjne, obejmujące narządy wewnętrzne, stanowią zupełnie inne wyzwanie. Dotykają przede wszystkim osób z obniżoną odpornością — po przeszczepach, w trakcie leczenia nowotworów, po intensywnej terapii czy z ciężkimi chorobami płuc. W tych sytuacjach grzyby, które zwykle bytują na skórze lub w przewodzie pokarmowym, mogą przedostać się do krwi i tkanek.
„Około 1,5 miliona osób rocznie doświadcza infekcji Candida we krwi lub inwazyjnej kandydozy, z czego blisko 64 procent umiera” — wskazują autorzy raportu opublikowanego w „The Lancet Infectious Diseases” .
Nowe patogeny i oporność
Największe zaniepokojenie specjalistów budzi pojawienie się szczepów odpornych na leczenie. Jednym z nich jest Candida auris, wykryta po raz pierwszy w 2009 roku, dziś obecna na sześciu kontynentach. Jak podkreśla raport brytyjskiej Agencji Bezpieczeństwa Zdrowotnego, „Candida auris budzi szczególne obawy, ponieważ w odróżnieniu od większości grzybów może przenosić się z człowieka na człowieka”. Infekcje tymą drobnoustrojem są trudne do rozpoznania i często oporne na dostępne leki.
Podobne zagrożenie stanowią grzyby z rodzaju Aspergillus. W przeglądzie opublikowanym w „News Medical” badacze zwracają uwagę, że inwazyjna aspergiloza staje się coraz częstsza wraz ze wzrostem liczby pacjentów z obniżoną odpornością. Jednocześnie coraz częściej obserwuje się oporność na azole — podstawową grupę leków przeciwgrzybiczych. Jak zauważa prof. Oliver Cornely z Uniwersytetu w Kolonii, współautor międzynarodowych wytycznych leczenia kandydozy: „Dzięki tym rekomendacjom wykonaliśmy ważny krok w stronę poprawy terapii pacjentów na całym świecie”.
Grzybice układowe często pozostają nierozpoznane. Objawy — gorączka, osłabienie, duszność — są niespecyficzne, a testy diagnostyczne wciąż nie są rutynowo dostępne w wielu szpitalach. „Kluczowe przesłanie dla lekarzy brzmi: ‘myśl o grzybach’. Infekcje grzybicze często pozostają nierozpoznane, ponieważ nie są brane pod uwagę w pierwszej kolejności” — mówi prof. Denning w rozmowie z „Evolving Health Journal”. Brak szybkiej diagnostyki i doświadczenia w interpretacji wyników powoduje, że wiele infekcji jest wykrywanych zbyt późno.
Grzyby zabijają w sposób cichy i trudny do wykrycia. W przeciwieństwie do bakterii nie wytwarzają toksyn, lecz stopniowo przejmują kontrolę nad tkankami gospodarza, wykorzystując jego własne mechanizmy obronne przeciwko niemu. W przypadku infekcji układowych – takich jak aspergiloza, kryptokokoza czy kandydoza inwazyjna – komórki grzybów wnikają do krwiobiegu, osiadają w płucach, mózgu lub nerkach i tworzą kolonie odporne na działanie leków.
Jak tłumaczy prof. Neil Gow z University of Exeter, współautor raportu opublikowanego w „Nature Reviews Microbiology” (2024), „grzyby potrafią ukrywać się przed układem immunologicznym, a gdy organizm jest osłabiony, błyskawicznie wykorzystują tę słabość”.
Jak wynika z analizy opublikowanej w „American Journal of Infectious Diseases”, inwazyjne infekcje grzybicze, choć rzadziej opisywane niż bakteryjne czy wirusowe, wiążą się z równie wysoką śmiertelnością. Autorzy podkreślają, że od początku XXI wieku grzyby stały się jednym z głównych globalnych zagrożeń zdrowotnych, zwłaszcza w kontekście starzenia się społeczeństw i rozwoju terapii immunosupresyjnych.
W poszukiwaniu nowych leków
Leczenie grzybic układowych opiera się na lekach przeciwgrzybiczych — najczęściej echinokandynach, azolach lub amfoterycynie B. W wielu przypadkach konieczne jest też usunięcie zakażonych cewników lub tkanek. Jednak, jak zauważa zespół z Uniwersytetu w Sewilli, „wyniki leczenia inwazyjnych infekcji grzybiczych pozostają niezadowalające, mimo dostępności nowych leków przeciwgrzybiczych”. Wciąż brakuje preparatów o szerokim spektrum i mniejszej toksyczności.
W ostatnich latach pojawiły się jednak nowe wytyczne, które mają ujednolicić postępowanie na świecie. Opracowana przez European Confederation of Medical Mycology i International Society for Human and Animal Mycology dokumentacja ma ułatwić diagnostykę i dobór terapii. Coraz więcej krajów wdraża też systemy monitorowania oporności grzybów, podobne do istniejących już dla bakterii.
Rosnąca liczba przypadków inwazyjnych grzybic sprawia, że naukowcy poszukują skuteczniejszych metod diagnostycznych — szybszych testów molekularnych i biomarkerów umożliwiających wczesne wykrycie infekcji. Badane są również nowe grupy leków i szczepionki przeciwgrzybicze. Program European Fungal Infection Network (EFIN) integruje ośrodki z Europy i Ameryki w celu opracowania zharmonizowanych standardów badań klinicznych.
Denning i współpracownicy w podsumowaniu swojego raportu piszą: „Poprawa świadomości klinicznej, odpowiednie pobieranie próbek i szybka diagnostyka laboratoryjna mogą znacząco zmniejszyć liczbę przedwczesnych zgonów z powodu chorób grzybiczych”. To jasny sygnał, że w walce z grzybami kluczowe są wiedza i szybkość działania.
Jak zauważa prof. Cornely: „Grzyby nie czekają. Jeśli nie rozpoznamy ich w porę, stracimy szansę na skuteczne leczenie.” Dziś, gdy liczba zakażeń rośnie, a świadomość pozostaje niska, ta przestroga brzmi bardziej aktualnie niż kiedykolwiek.
Grzybice układowe nie są problemem odległych regionów ani egzotycznych patogenów. To zjawisko, które rozwija się w cieniu współczesnej medycyny — w szpitalach, gdzie leczenie ratuje życie, ale też czasem otwiera furtkę dla nowych zagrożeń. Zrozumienie ich natury i włączenie w codzienną praktykę kliniczną odpowiednich procedur może zadecydować o skuteczności systemu ochrony zdrowia w najbliższych dekadach.







